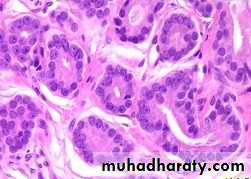
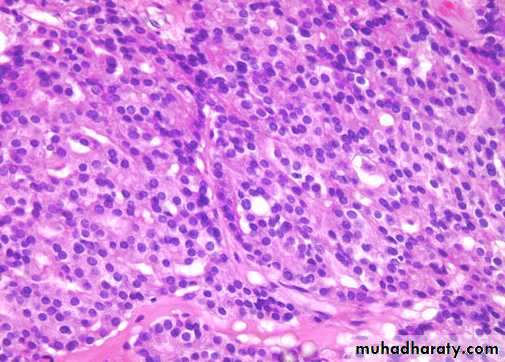
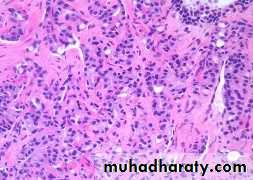
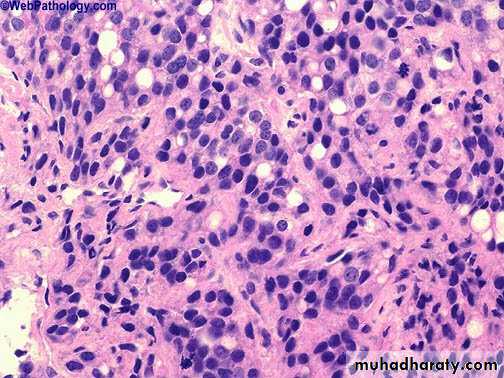

Prostate Cancer
Carcinoma of the prostate
Is the second most common cause of cancer related death in men older than 50 years of age after carcinoma of the lung with peak incidence between the ages of 65-75 years.Autopsy studies show that 30% to 40% of men over 50, who had no symptoms of prostate cancer whilst alive, have histological evidence of prostate cancer at the time of death. This percentage rises to 60% to 70% in men over 80 years of age.
Proposed Risk Factors
Family historyDiet, fat, obesity, alcohol
Hormones
Smoking
Sexual activity (early, multiple partners, STD)
Chemicals, toxins, radiation
Viruses (Herpes 2, CMV)
Vasectomy
BPH
Pathology:- 70-80% of Ca prostate arise in the outer peripheral glands and hence may be palpable as irregular hard nodules by rectal digital examination and because of its peripheral location. Ca prostate less likely to cause urethral obstruction in early stage than nodular hyperplasia.
Grossly:- early lesions appear as ill defined mass just beneath the capsule of the prostate. On cut section foci of CA appear as firm gray white to yellow lesions that infiltrate the adjacent gland with ill defined margin.
Metastases to regional pelvic lymph nodes may occur early. In advance cancers invasion to seminal vesicles, periurethral zones of the prostate, wall of the bladder may occur but the rectum is rarely involved by invasion that is because there is a connective tissue separating the lower genitourinary tract structures from the rectum which prevent the growth of the tumor posteriorly.
Well differentiated adenocarcinomas are composed of small glands infiltrate the adjacent stroma in irregular haphazard fashion. In contrast to normal and hyperplastic prostate
the glands in carcinoma doe not encircled by collagen or stromal cells but they appear to have (back to back) appearance.
The neoplastic glands are lined by a single layer of cuboidal cells with conspicuous nucleoli;( the basal layer seen in normal and hyperplastic glands is absent).
The undifferentiated adenocarcinoma characterized by
1) increasing variability of gland size and configuration2) papillary and cribriform patterns
3) some times there is no gland formation but there is a solid cord or sheet of infiltrating malignant tumor cells within the stroma.
Clinical features: Ca prostate are often clinically silent especially during early stages, but
20% of localized ca are discovered accidently during histological examination for biopsy removed for nodular hyperplasia.
Discovered accidently during routine digital rectal examination as hard firm nodules under the capsule of peripheral glands.
More extensive Ca may produce signs and symptoms of prostatism due to lower UT obstruction.
More aggressive tumor may give clinical presentation of metastases. Bone metastases especially to axial skeleton is the most common and prostatic Ca may cause either osteolytic (destructive lesion) or more commonly osteoblastic lesions(bone producing lesions).
The presence of osteoblastic metastases is strongly suggestive of advance prostatic Ca.
Bone Metastases
Spinal mets ->
Painful
May cause lots of reactive bone growth at the site of the met
Osteoblastic
May cause bone destruction
Osteolytic
Microscopically:- most Ca prostate are adenocarcinomas with variable degree of differentiation. They originate from intraductal dysplastic foci termed prostatic intra epithelial neoplasia (PIN) which is a premalignant state in which the prostatic ducts lined by cytologically a typical luminal cells and a concomitant diminution in the number of the basal cells.
PIN is of low and high grade patterns and it precedes the appearance of invasive carcinoma by two decades and there severity increases with increasing age.
Gleason system
Based on architectural patternCytological features not factored in
Overall grade is not based on highest grade component
Score = Primary pattern (1-5)+ secondary pattern (1-5)
Pattern 1
Pattern 2
Gleason Pattern 3
Pattern 3
Pattern 4
Gleason Pattern 5
Prostate Cancer
Diagnostic tests
DREPSA
TRUS
To identify lesions of suspected malignancy
To improve the accuracy of prostate biopsies
Prostate biopsies
Causes of increased incidence
• A- Early detection:
• PSAprostatic –specific antigen (PSA) is proteolytic enzyme produced by both normal and neoplastic epithelium. It secreted into prostatic acini then into the seminal fluid where it increases the motility of the sperm by maintaining the seminal secretion in a liquid state.
It s upper normal limit value 4ng/L. it is used in the diagnosis of early Ca but it is of limited that due to
Causes of Raised PSA:
Prostaitc cancerBPH
Prostatic infarction
Prostatic manipulation
Prostatic biopsy
Acute urinary retention
Urethral catheterisation
Age related reference limits:
<49y50-59y
60-69y
70-79y<2.5 g/l
<3.5
<4.5<6.5
2. Digital Rectal Examination (DRE)Early Detection
3. TRUS and Biopsy
Early Detection
TRUS4. Increased awareness
Early Detection
Causes of Increased Incidence
B. Longer life
Incidence versus Age
Rare < 40latent cancer (at autopsy) =
10% at 50 years80% by 80 years
Grading of Prostatic Ca.Gleason’s SystemGrades 1-5
Scores 2-10
Strongest predictor of biologic behaviour
Should be included with other prognostic factors in therapeutic decision making
e.g- age, health status, clinical stage, PSA
The most common treatments for prostate cancer include :
Surgery
external beam radiotherapy
hotmone therapy,
radioactive seed implants(internal radiotherapy),
watchful waiting
The most common treatments for prostate cancer include :
Surgeryexternal beam radiotherapy
hotmone therapy,
radioactive seed implants(internal radiotherapy),
watchful waiting
The most common treatments for prostate cancer include :
Surgeryexternal beam radiotherapy
hotmone therapy,
radioactive seed implants(internal radiotherapy),
watchful waiting
The most common treatments for prostate cancer include :
Surgery
external beam radiotherapy
hotmone therapy,
radioactive seed implants(internal radiotherapy),
watchful waiting
The most common treatments for prostate cancer include :
Surgeryexternal beam radiotherapy
hotmone therapy,
radioactive seed implants(internal radiotherapy),
watchful waiting
Transitional cell carcinoma
3 types are identified:• Direct extension/invasion from the bladder
• Spread from the bladder along prostatic ducts• Primary TCC of prostatic urethral lining with no lesion in bladder
Mesynchymal Tumours
Phyllodes (Benign & Malignant)STUMP
Leiomyoma & Leiomyosarcoma
Spindle cell nodule (post operative)
Pseudosarcomatous fibromyxoid tumour
Solitary fibrous tumour
Embryonal rhabdomyosarcoma
Dilemma of Prostate Cancer
30 - 50% of patients undergoing radical surgery for localised disease have extra capsular extension at the time of surgery.Current staging tests are inadequate to accurately identify these patients.
THE FUTURE ?1- PIN versus CANCER
The Future2- To understand the biological behaviour of prostate cancer
The Future2- To understand the biological behaviour of prostate cancer
The Future